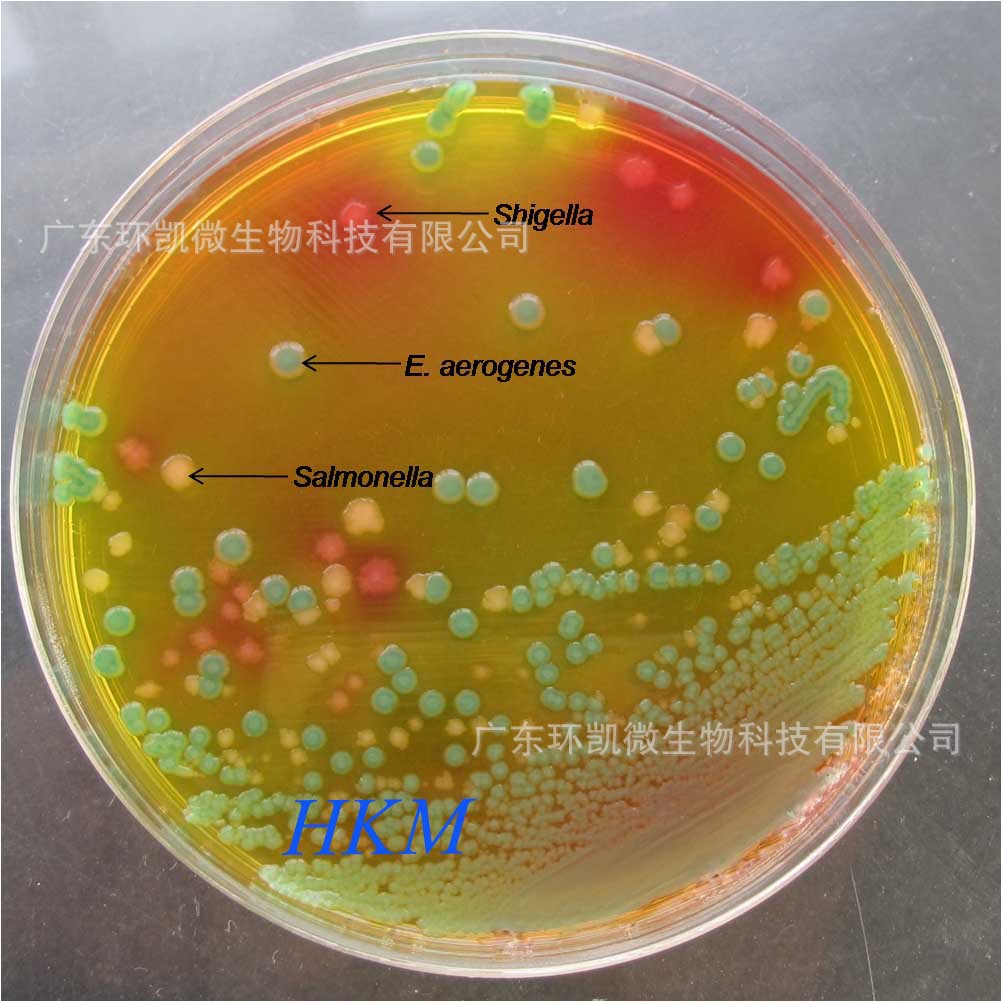
志贺氏菌显色培养基

志贺菌培养

宋内志贺氏菌(Ⅰ项)ss培养基19h培养
图片尺寸690x690
志贺氏菌培养皿
图片尺寸2252x2200
志贺氏菌显色培养基平板9cm培养皿科玛嘉原料细菌培养皿 十个2f包 十
图片尺寸800x800
食品中志贺氏菌检验简单介绍上
图片尺寸2368x1908
福氏志贺氏菌志贺氏菌显色培养基
图片尺寸650x650
痢疾志贺氏菌_北纳生物bncc103609_技术参数_价格-仪器网
图片尺寸379x209
志贺氏菌显色培养基的应用
图片尺寸436x350
沙门,志贺菌属琼脂培养基(ss)的应用
图片尺寸368x350
志贺氏菌检验中重要培养基的应用
图片尺寸620x491
2志贺氏菌在半固体琼脂上的生长情况志贺氏菌在半固体培养基中无动力
图片尺寸4018x1988
志贺氏菌显色培养基
图片尺寸1002x1002
志贺氏菌显色培养基
图片尺寸546x545
半固体培养基志贺氏菌在半固体
图片尺寸2754x2434
临床常见微生物图谱——鲍氏志贺菌
图片尺寸500x421
沙门志贺菌属琼脂ss对照培养基
图片尺寸545x182
宋内志贺氏菌(Ⅰ项)血平板24h培养
图片尺寸595x600
食品论坛
图片尺寸553x544
陆桥志贺氏菌显色培养基
图片尺寸800x800
环凯志贺氏菌检测显色培养基
图片尺寸1024x767
志贺氏菌显色培养基
图片尺寸5760x3840